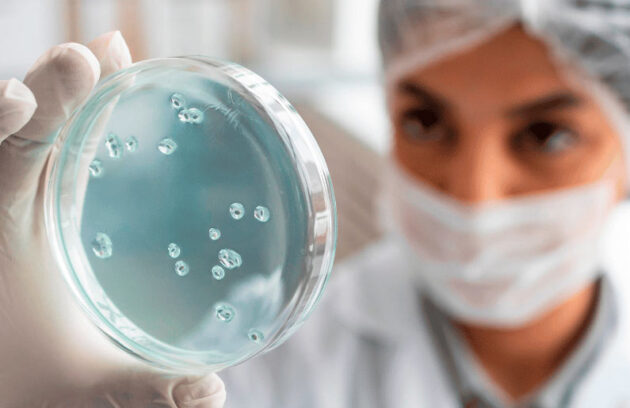
spx-clinica-spx-imagem-nova-terapia-celular-contra-o-cancer

A degradação de proteínas tumorais torna-se um promissor método de combate ao câncer, a fim de desestabilizar esse mal!
Você sabe o que os selos de qualidade CBR da SPX representam tanto para a clínica quanto aos nossos pacientes?…
Pesquisadores utilizaram um RNA mensageiro e elucidaram por que a vacina é importante para cura do HIV. Saiba mais!
Presente em nosso corpo, descubra como o metal lítio pode combater o Alzheimer e assegurar o funcionamento cerebral, segundo pesquisa
Com a utilização de células CAR-T, entenda como essa terapia celular contra o câncer se mostra inovadora para o tratamento!
Você sabe identificar quando uma criança precisa de ajuda? Conheça os principais sinais de sofrimento psíquico infantil
Você sabe quais os sinais da ansiedade infantil? Compreenda esse cenário, que aumentou consideravelmente nos últimos anos!
Confira algumas práticas simples e importantes para combater sintomas de ansiedade e depressão, e recupere sua qualidade de vida!
Descubra tudo sobre a especialidade médica vascular, além de quando e por quais motivos consultar esse médico
Recorrido por algumas pessoas com o vírus do Aedes Aegypti no corpo, descubra se o inhame ajuda a combater a…